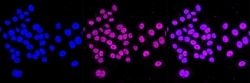
Invitrogen TEF1 Recombinant Rabbit Monoclonal Antibody (23GB2795), Invitrogen

missing translation for 'onlineSavingsMsg'
Learn More
Learn More
Invitrogen™ TEF1 Recombinant Rabbit Monoclonal Antibody (23GB2795), Invitrogen™


Rabbit Recombinant Monoclonal Antibody
Brand: Invitrogen™ MA553580
This item is not returnable.
View return policy
Description
TEF1 (Transcriptional enhancer factor 1), a member of the TEA/ATTS domain family, is a nuclear protein that is expressed in numerous cell types and plays a role in controlling the expression of numerous genes. TEF family members have a highly conserved DNA-binding domain TEF-1 binds to GT-IIC, SphI/II and M-CAT. TEF-1 also binds to the proximal regulatory element (PRE) of transforming growth factor-alpha, a member of the EGF family that is overexpressed in many types of cancer. Furthermore, TEF-1 represses transcription in placental cells. In vitro, TEF-1 is phosphorylated by several PKC isozymes. TEF-1 is phosphorylated in vivo at serine and threonine residues. Phosphorylation of TEF-1, both in vivo and in vitro, results in a reduction in its DNA-binding capability, which suggests a potential role for TEF-1 in PKC inhibition. TEF-1 also complexes with larger tumor antigen (TAg), and may thus have a role in tumorigenesis. Dimerization of TEF-1 may be important for TEF-1 to function as a regulator of gene transcription.
Specifications
| TEF1 | |
| Recombinant Monoclonal | |
| Unconjugated | |
| Tead1 | |
| 2610024B07Rik; AA; B230114H05Rik; Gtrgeo5; mTEF-1; N TEAD1; NTEF1; NTEF-1; protein GT-IIC; REF1; Tcf13; TCF-13; TEA domain family member 1; TEA domain family member 1 (SV40 transcriptional enhancer factor); TEA domain transcription factor 1; TEAD1; TEAD-1; TEF1; TEF-1; Transcription factor 13; transcriptional enhancer factor 1; transcriptional enhancer factor TEF-1 | |
| Rabbit | |
| Affinity chromatography | |
| RUO | |
| 21676, 361630, 7003 | |
| -20°C | |
| Liquid |
| Flow Cytometry, Western Blot, Immunocytochemistry | |
| 23GB2795 | |
| PBS with 50% glycerol and 0.02% sodium azide; pH 7.4 | |
| P28347, P30051 | |
| Tead1 | |
| A synthesized peptide derived from human TEAD1 (1-45AA). | |
| 100 μL | |
| Primary | |
| Human, Mouse, Rat | |
| Antibody | |
| IgG |
Product Content Correction
Your input is important to us. Please complete this form to provide feedback related to the content on this product.
Product Title
Spot an opportunity for improvement?Share a Content Correction